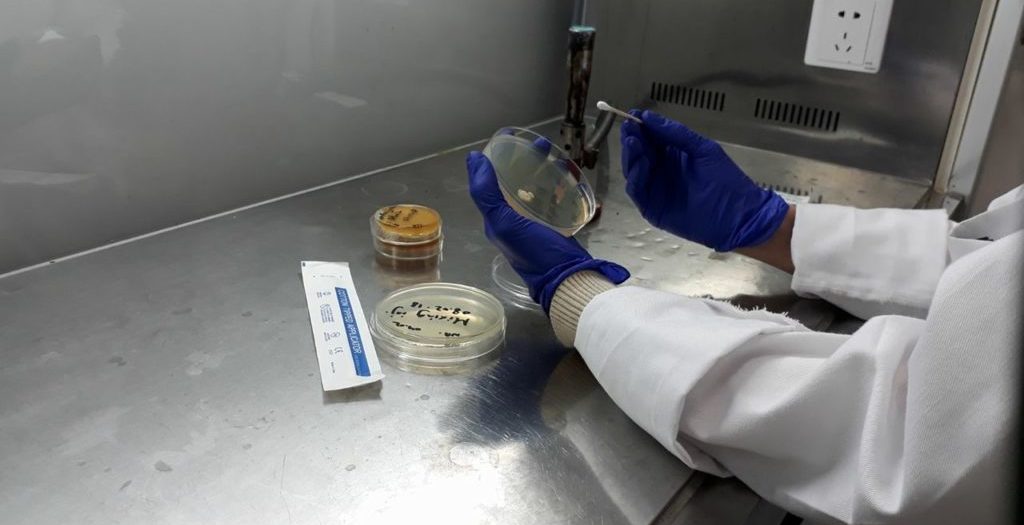
Animal health experts

-

Dana Pharmaceuticals
Dana Pharmaceuticals
-

A developed R&D unit
A unique R&D unit
-

We care about animal health
We care about animal health
-

Best quality standards in production
We work on the best international quality standards
-
Animal health experts
Animal health experts




